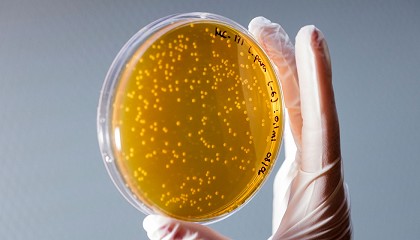

Resultados de la búsqueda "biodiesel"
El equilibrio en la carretera - 24/05/2022

biodiésel 100% renovable. Junto a este bloque, el Scania S500 combina también la nueva caja de cambios automatizada Opticruise G33, 60 kilos más ligera que la gama anterior. Esta caja
Caterpillar aporta la tecnología más avanzada a los trabajos de demolición - 21/01/2021

biodiésel hasta B20. Tres modos de potencia permiten al operador adaptar el rendimiento de la máquina a la tarea en cuestión, y un nuevo ventilador hidráulico reversible de alta eficiencia
El MITECO destina 177 millones a impulsar 544 proyectos de energías renovables innovadoras - 21/01/2022

biodiesel, en Valdetorres, en una de producción de combustibles sintéticos. Se trata de un proyecto singular e innovador que cuenta con una potencia fotovoltaica de 4,5 MW y 1,25 MW de electrólisis
Camino hacia la sostenibilidad - 23/03/2022

biodiésel. Ambos con una masa máxima autorizada de conjunto de hasta 29 toneladas. Volta Trucks realizó un tour por Europa para presentar su prototipo, el Volta Zero. Un camión totalmente
Cereales y oleaginosas se dan la vuelta y caen con fuerza en los mercados - 25/06/2021

biodiésel en el combustible. Esto reduciría la cantidad de aceite de soja necesaria para fabricar biodiésel. También hay incertidumbre sobre los niveles de demanda en Asia. La evolución del cultivo
Tamoil incrementa su presencia en la provincia de Alicante - 12/07/2021

biodiésel, gasolina 95, gasolina 98 y AdBlue, todos ellos incorporados a los programas Tamoil Club y mycard, que permite a los usuarios disfrutar de atractivos descuentos. La estación de servicio
Envac publica su primera memoria de sostenibilidad - 20/07/2021

biodiésel HVO, que reducen significativamente las emisiones de CO2, así como bolsas hechas de plástico reciclado en sus sistemas para promover la economía circular, entre otras medidas. Nueva herramienta de comunicación
Un reto gigantesco - 04/11/2021

biodiésel y bioetanol, entre otros) que deben cumplir los estrictos criterios de sostenibilidad de la Directiva de fomento del uso de energía procedente de fuentes renovables. Otra posibilidad es la obtención
Atlas Copco presenta la nueva gama de bombas de achique PAS HardHat - 23/07/2021

biodiésel, para reducir la huella de carbono del propio producto. Las bombas están disponibles en tres opciones de diseño (independiente o con chasis o patín galvanizado) que las hace ideales
Investigan el cultivo de planta considerada mala hierba con efecto biofumigante para producir biodiesel aprovechando el barbecho - 11/02/2019
biodiesel aprovechando el barbecho - 11/02/2019: Investigan el cultivo de planta considerada mala hierba con efecto biofumigante para producir biodiesel aprovechando el barbecho Redacción laagriculturadigital.com La Estación Experimental Aula Dei-CSIC
Tamoil amplía su presencia en Andalucía - 28/04/2021

biodiesel, gasolina sin plomo 95 y AdBlue, combustible y carburantes incorporados en los programas de fidelidad Tamoil Club y mycard, que permite a los usuarios disfrutar de descuentos, ofertas y regalos
Un sector en auge: la microbiología industrial - 24/05/2021
biodiésel, la generación de ácidos orgánicos, o la producción de proteínas y enzimas. Hoy en día, un caso muy conocido por todos son las enzimas de los kits de PCR para
Economía circular, la llave para la independencia energética y el uso optimizado del agua en las ciudades del futuro - 08/09/2021

biodiesel y biogás, así como sustrato para la fertilización de cultivos. Enel X y Cetrel han pasado a formar parte de un selecto grupo de empresas (junto a Siemens y SegurPro
Fycma abordó la movilidad sostenible con un debate enmarcado en la EU Greeen Week - 07/06/2021

biodiesel y glicerina a partir de él y así alimentar a la flota pública valenciana de transportes. Por otro lado, mencionó el programa LIFE Ecodigestión 2.0, una iniciativa que permite
Comportamiento del consumidor de aceite de oliva en el mundo, España y Andalucía - 15/09/2021

biodiesel, siendo el aceite de palma mayoritario como materia prima. Consumo de aceites de oliva y caracterización del consumidor en Andalucía En Andalucía se consumen casi 450 mil toneladas de aceites
Los alimentos experimentan en el último mes la subida más grande de toda la década a nivel mundial - 07/06/2021

biodiésel, impulsaron los precios del aceite de soja. El índice de precios del azúcar de la FAO aumentó un 6,8% respecto de abril, principalmente a causa de los retrasos
Álvaro Mitjans, nuevo presidente de APPA Biocarburantes - 17/03/2021

biodiésel situadas en Castellón, Ferrol y Cartagena. Natural de Madrid, Álvaro Mitjans es licenciado en ciencias económicas y administración de empresas por CUNEF, desarrollando su carrera profesional durante más de diez
Álvaro Mitjans, nuevo presidente de APPA Biocarburantes - 11/03/2021

biodiésel situadas en Castellón, Ferrol (A Coruña) y Cartagena (Murcia). Natural de Madrid, Álvaro Mitjans es licenciado en Ciencias Económicas y Administración de Empresas por CUNEF, y ha desarrollado su carrera
Duplican la velocidad de crecimiento de microalgas con residuos del vino para obtener biocombustible - 02/10/2019

biodiésel. Los expertos han combinado estos organismos con la reutilización de los residuos para lograr una producción de biocombustibles más barata y mejorar la economía general del proceso al promover
La recogida neumática en España evita al año el recorrido de 364.000 kilómetros de camiones pesados por las calles - 17/12/2020

biodiesel, estimando que, por cada trazado de ruta urbana que se realiza con las intersecciones y trazados necesarios, se recorren 30 km y se consumen en torno a 45 l/100
